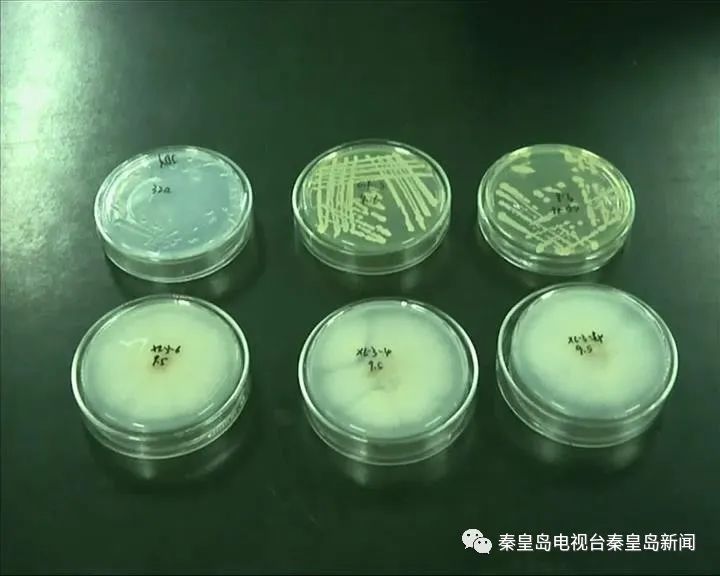

2021年10月31日,秦皇岛电视台《秦皇岛新闻》栏目就花生果腐病综合防控技术相关内容采访了开云官网孙伟明教授。

“花生是我国主要油料作物和经济作物之一。近年来,花生果腐病日趋严重,为降低烂果率,提高花生产量,科研人员在明确花生果腐病发病机制的基础上,研制复合微生物肥料,实现花生果腐病的综合防控。

眼下,正是花生收获的季节。在唐山扣庄村的花生果腐病综合防控技术试验示范基地里,开云kaiyun官网副教授孙伟明和他的科研团队,正在和合作社的工作人员,一起查看花生果腐病的防治效果。
花生果腐病又称为“花生烂果病”,染病地块会减产20%到50%以上,该病害已成为花生种植上的一种主要病害,对花生的产量和品质构成了极为严重的威胁。

为打破花生果腐病防治的瓶颈,孙伟明带领科研团队从病原菌、土壤理化性质、微生物群落和气候条件四方面探索花生果腐病发生机制,从而确定了实验角度和方向。
在初步明确发病机制的基础上,科研团队筛选生防内生菌和具有生防、解磷、解钾、降解自毒物质的根际微生物,研制微生物菌系和有机无机相复配的复合微生物肥料,并配合田间管理技术,进行综合防控技术的探索。
通过对示范基地现场抽样实测结果显示,此项技术可显著降低花生果腐病的病情指数,防治效果在85%以上,比发病区的产量高40%以上,对保障花生产业健康发展,实现农民增产增收具体重要意义。
此外,由于花生果腐病综合防控技术是采取底施肥的方式进行防控,在使用上也非常便利。
目前,孙伟明团队研发的“花生果腐病综合防控技术”已经通过了河北省科技厅组织的专家现场检测。下一步,他们将进行多点示范。”
观看完整视频请点击